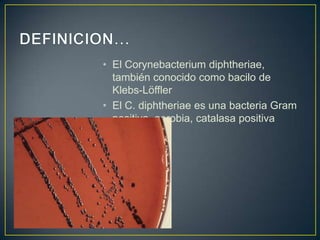
• El Corynebacterium diphtheriae,
también conocido como bacilo de
Klebs-Löffler
• El C. diphtheriae es una bacteria Gram
positiva, aerobia, catalasa positiva
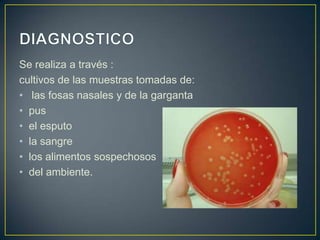
Se realiza a través :
cultivos de las muestras tomadas de:
• las fosas nasales y de la garganta
• pus
• el esputo
• la sangre
• los alimentos sospechosos
• del ambiente.
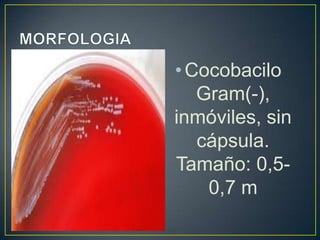
•Cocobacilo
Gram(-),
inmóviles, sin
cápsula.
Tamaño: 0,5-
0,7 m

Este documento describe la bacteria Bacillus anthracis, que causa la enfermedad del ántrax. B. anthracis es una bacteria grampositiva que forma esporas y puede infectar a humanos y animales. Cuando infecta ganado, la bacteria se reproduce dentro del animal y puede causar la muerte, luego produciendo nuevas esporas que continúan el ciclo. El ántrax puede transmitirse a través de la inhalación de esporas, el consumo de carne contaminada o el contacto con tejidos infectados. La penicilina es el antibiótico de